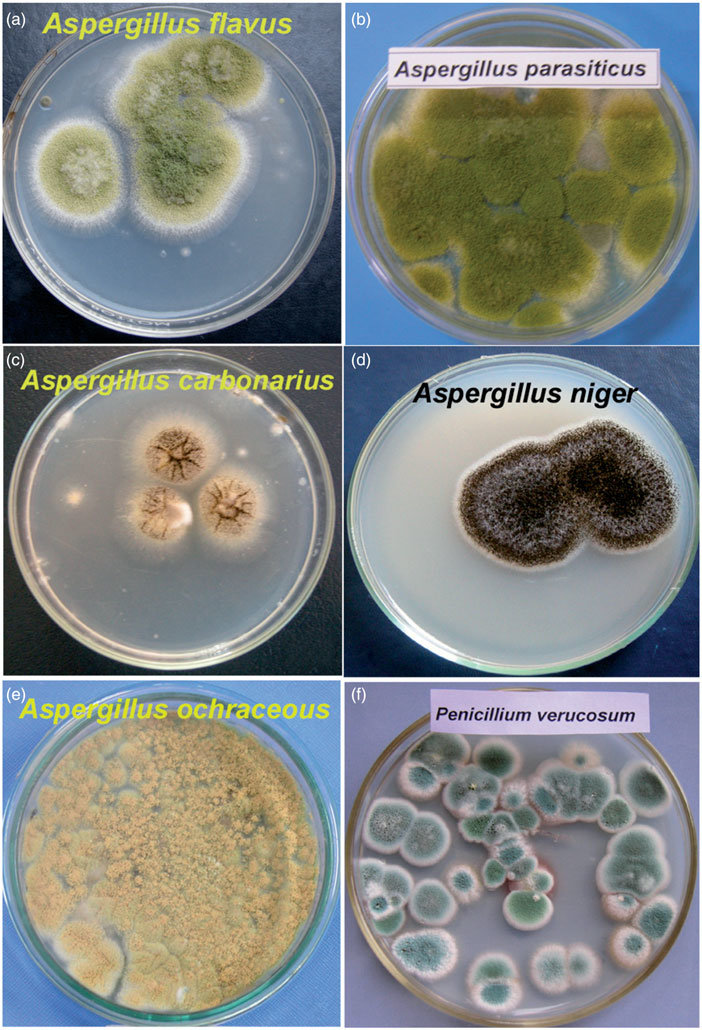
Czapek Dox Agar - Source:  M.K. Saleemi et al. DOI:10.1080/15569543.2016.1233890

Czapek mediumis also called Czapek’s agar (CZA) or Czapek-Dox medium. Czapek agar is named after the Friedrich Johann Franz Czapek. He invented this medium and was later modified by Arthur Wayland Dox. Thus the name Czapek-Dox medium is derived. It is used for the general cultivation of fungi from the water sample and the cultivation of saprophytic fungi and soil bacteria. Sucrose and nitrate are the sources of carbon and nitrogen, respectively.
The modified form of the Czapek Dox Agar is the Oxoid Czapek Dox Agar. This modified form prevents the precipitation of magnesium phosphate. The medium has good buffering action due to the presence of different salts. It highly supports Candidaalbicans**for chlamydospore production.
Principle of Czapek Dox Agar
Czapek Dox Agar is the semisynthetic medium used to cultivate fungi (yeasts, molds, filamentous species). Sodium nitrate is the sole nitrogen source, while sucrose is the sole carbon source. Czapek Dox Agar is used to isolate the Aspergillus, Penicillium, Paecilomyces, and other fungi having the same requirement. Dipotassium phosphate buffers the medium. The essential ions required for the medium is provided by magnesium sulphate, potassium chloride, and ferrous sulphate. Agar present in the medium is the solidifying agent. In the modified form of the Czapek Dox Agar, the magnesium glycerophosphate and potassium sulfate have replaced the magnesium sulfate and potassium phosphate of the media. This modification helps to prevent the precipitation of magnesium phosphate.
Composition ofCzapek Dox Agar
| Ingredients | Gms/ Litre |
|---|---|
| Sucrose | 30.000 |
| Sodium nitrate | 2.000 |
| Dipotassium phosphate | 1.000 |
| Magnesium sulphate | 0.500 |
| Potassium chloride | 0.500 |
| Ferrous sulphate | 0.010 |
| Agar | 15.000 |
| Final pH (at 25°C) | 7.3 ± 0.2 |
Preparation of Czapek Dox Agar
- Take 1000 ml distilled water and suspend 49.01 grams.
- To dissolve properly, heat the mixture till it boils gently.
- Then sterilize it in the autoclave at 15 lbs pressure (121°C) for 15 minutes.
- After the sterilization, cool it to 45-50°C.
- Before pouring in the sterile plates, mix them properly. If it is not mixed well, agar may sediment at the bottom, due to which the media plates do not set well due to the improper aliquot of the agar.
Colony Characteristics in Czapek Dox Agar
Candida albicans: cream-colored colonies
Aspergillus niger: White/yellow mycelium, black spores
Aspergillus flavus: granular, flat, often with radial grooves and yellow
Figure: Colonies of different fungal species on Czapek dox solution agar media after incubation at 27°C for 4-5 days. (a)A. flavus, (b) A. parasiticus, (c) A. carbonarius, (d) A. niger, (e) A. ochraceous, and (f) P. verucosum.
Uses
- Czapek Dox Agar is used for the isolation of Aspergillus, Penicillium, Paecilomyces, and other fungi.
- It is used for testing water and wastewater samples to isolate the Aspergillus, Penicillium, and other fungi.
- Czapek medium is also used for the taxonomic studies of Penicillium.
- Acidophilic organisms like yeast can be cultivated in the Czapek Agar by increasing the acidity of the medium.
Limitation
It does not support the growth of fastidious organisms.
References
- Chander, J. (2018). Textbook of Medical Mycology (Fourth edition). Jaypee Brothers Medical Publishers Ltd.
- Saleemi, M. K., Khan, M. Z., & Khan, A. (2016). Study of fungi and their toxigenic potential isolated from wheat and wheat bran. Toxin Reviews, 0(0), 000. https://doi.org/10.1080/15569543.2016.1233890
- HIMEDIA Laboratories. (2015). Czapek Dox Agar Specimen Collection and Handling: Warning and Precautions: Limitations: 6–9.